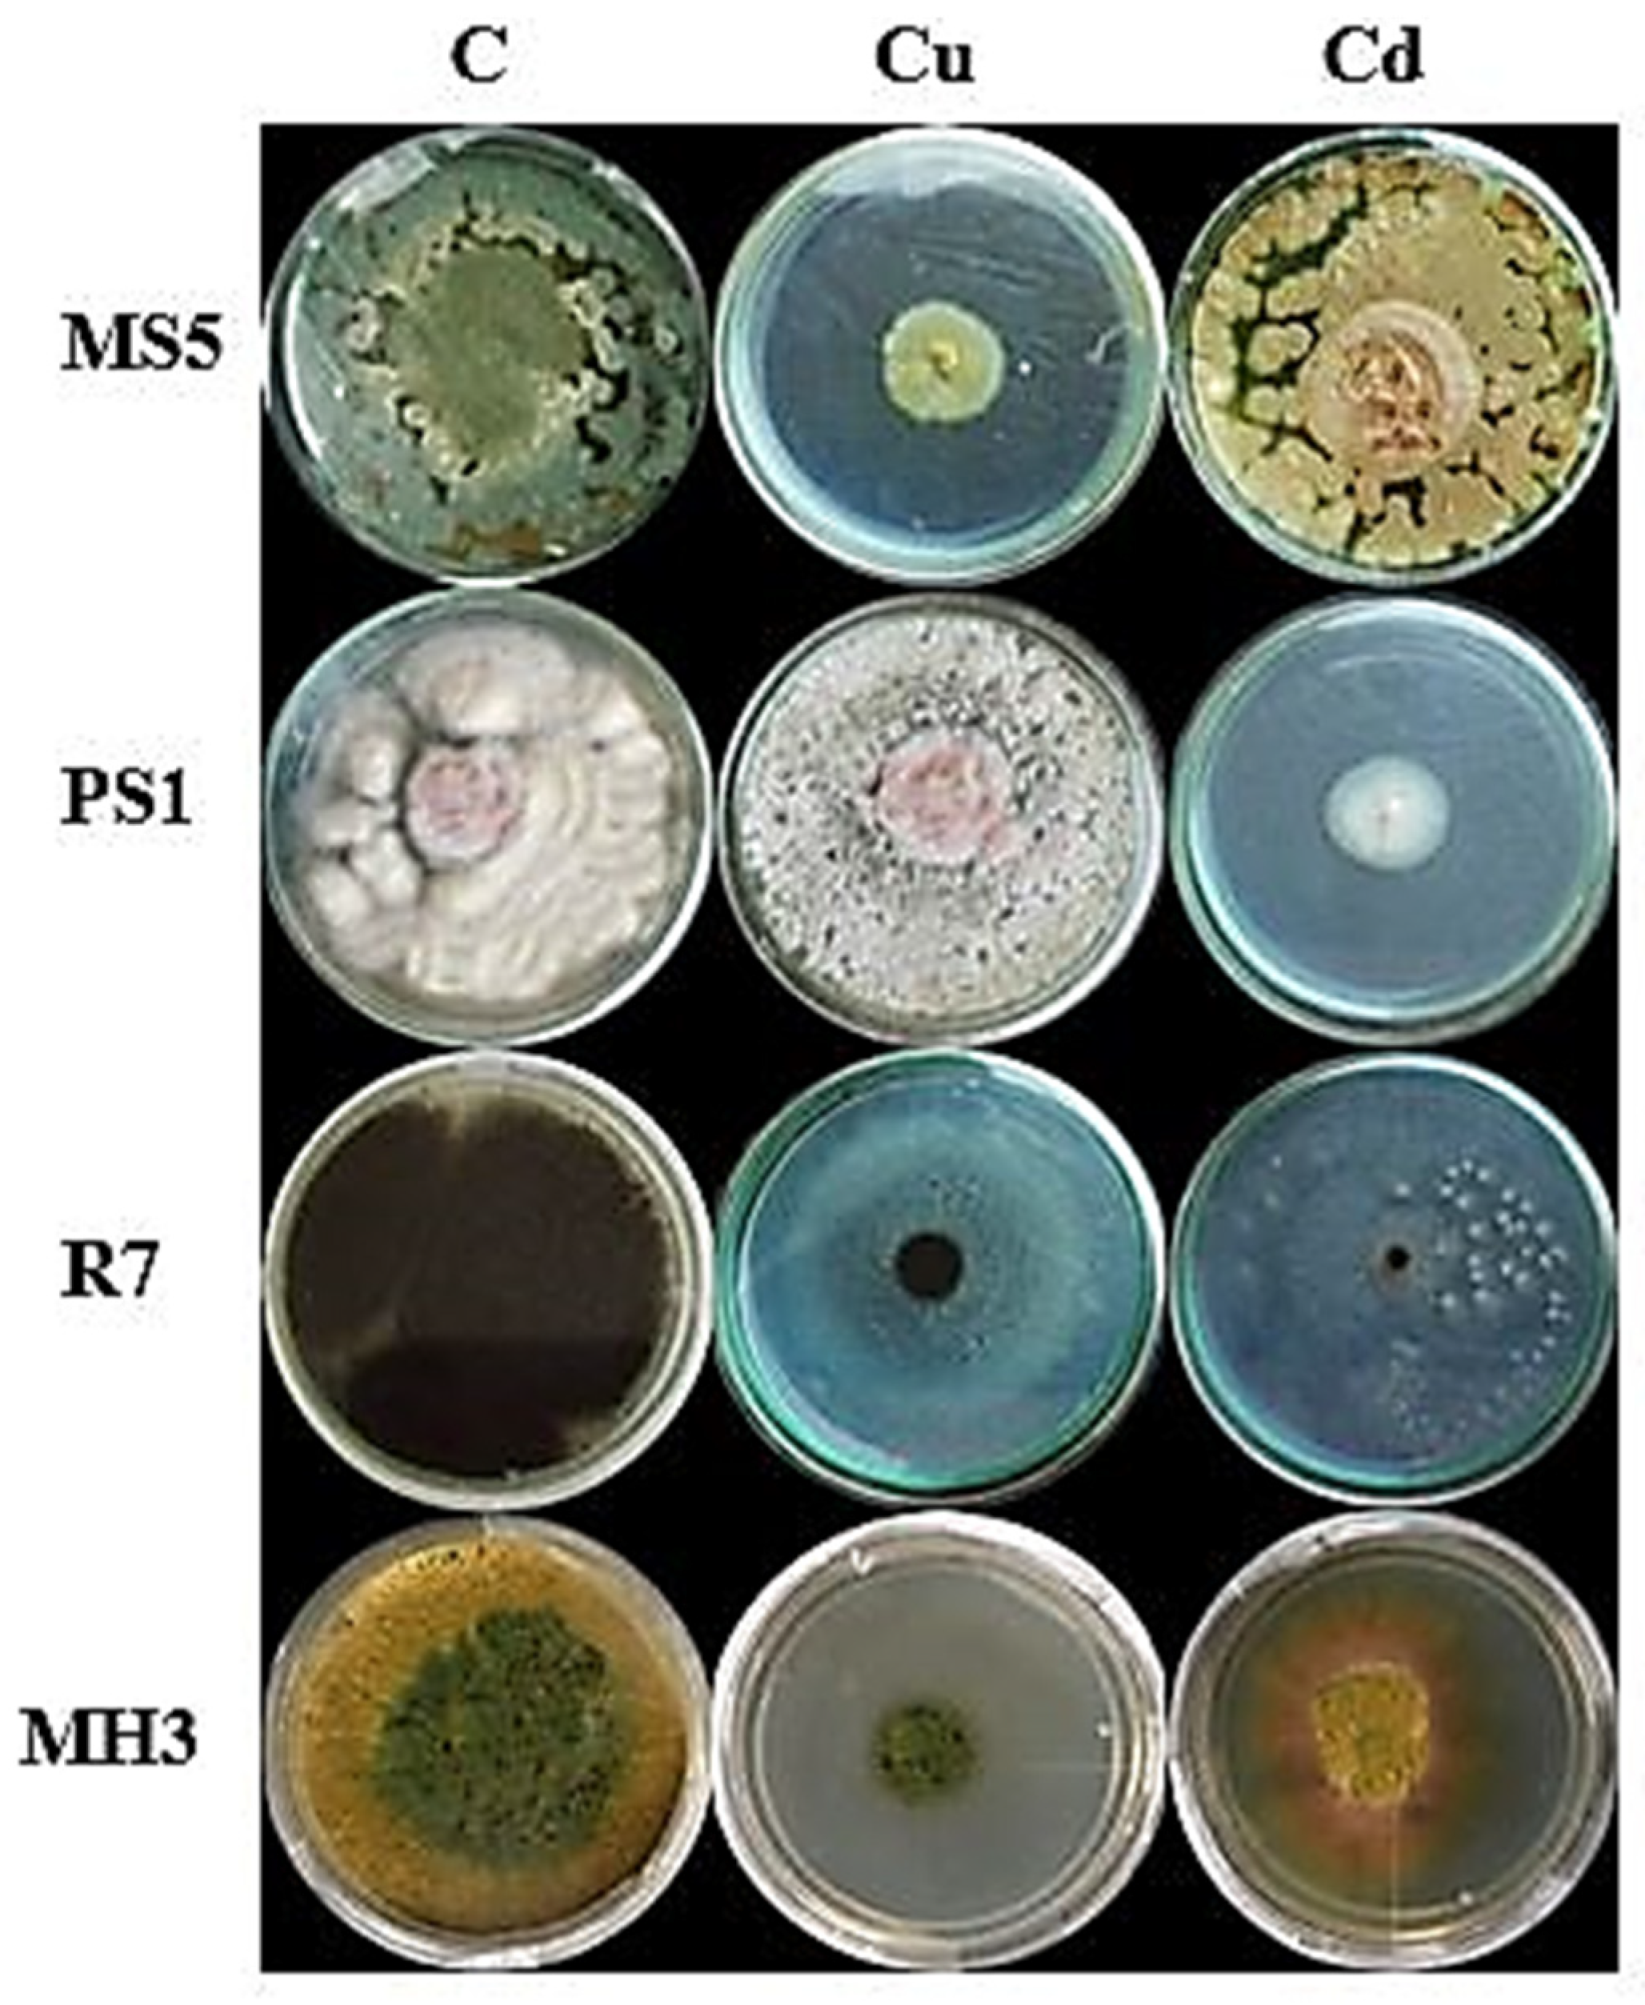
Sustainability 14 05531 g005

Preservation and Recovery of Metal-Tolerant Fungi from Industrial Soil and Their Application to Improve Germination and Growth of Wheat
Abstract
:1. Introduction
2. Material and Methods
2.1. Reagents and Instruments
2.2. Soil Sample Collection and Processing
2.3. Physiochemical Properties of Soil Samples
2.4. Screening and Identification of Selected Fungal Strains
2.4.1. Morphological Identification
2.4.2. Microscopic Identification
2.4.3. Molecular Identification
2.5. Minimum Inhibitory Concentration
2.6. Metal Tolerance Index
2.7. Biosorption Capacity of Isolated Fungi
2.8. Seed Germination Assay
2.9. Germination Rate
2.10. Root and Shoot Length
2.11. Statistical Analysis
3. Results
3.1. Physiochemical Properties of Soil
3.2. Contamination Factor (CF) and Geo-Accumulation Index (Igeo)
3.3. Pollution Index (PI)
3.4. Isolation and Screening of Fungi from Soil Sample
3.5. Macroscopic and Microscopic Identification of Isolated Fungi
3.6. Molecular Identification
3.7. Minimum Inhibitory Concentrations (MIC) and Tolerance Index (TI)
3.8. Morphological Variations
3.9. Biosorption Capacity
3.10. Seed Germination Assay
3.11. Root and Shoot Assay
4. Discussion
5. Conclusions
Author Contributions
Funding
Institutional Review Board Statement
Informed Consent Statement
Data Availability Statement
Acknowledgments
Conflicts of Interest
References
- Gavrilescu, M. Water, soil, and plants interactions in a threatened environment. Water 2021, 13, 2746. [Google Scholar] [CrossRef]
- Liaquat, F.; Haroon, U.; Munis, M.F.H.; Arif, S.; Khizar, M.; Ali, W.; Shengquan, C.; Qunlu, L. Efficient recovery of metal tolerant fungi from the soil of industrial area and determination of their biosorption capacity. Environ. Technol. Innov. 2021, 21, 101237. [Google Scholar] [CrossRef]
- Rajkumar, M.; Freitas, H. Influence of metal resistant-plant growth-promoting bacteria on the growth of Ricinus communis in soil contaminated with heavy metals. Chemosphere 2008, 71, 834–842. [Google Scholar] [CrossRef] [PubMed] [Green Version]
- Bungau, S.; Behl, T.; Aleya, L.; Bourgeade, P.; Aloui-Sossé, B.; Purza, A.L.; Abid, A.; Samuel, A.D. Expatiating the impact of anthropogenic aspects and climatic factors on long-term soil monitoring and management. Environ. Sci. Pollut. Res. 2021, 28, 30528–30550. [Google Scholar] [CrossRef]
- Lashen, Z.M.; Shams, M.S.; El-Sheshtawy, H.S.; Slaný, M.; Antoniadis, V.; Yang, X.; Sharma, G.; Rinklebe, J.; Shaheen, S.M.; Elmahdy, S.M. Remediation of Cd and Cu contaminated water and soil using novel nanomaterials derived from sugar beet processing-and clay brick factory-solid wastes. J. Hazard. Mater. 2022, 428, 128205. [Google Scholar] [CrossRef]
- Samuel, A.D.; Bungau, S.; Tit, D.M.; Melinte, C.E.; Purza, L.; Badea, G.E. Effects of long term application of organic and mineral fertilizers on soil enzymes. Rev. Chim. 2018, 69, 2608–2612. [Google Scholar] [CrossRef]
- Takhelmayum, G.; Savitha, A.L.; Krishna, G. Laboratory study on soil stabilization using fly ash mixtures. Int. J. Eng. Sci. Innov. Technol. 2013, 2, 477–482. [Google Scholar]
- Bansal, R.; Pfeiffer, S.E. Novel stage in the oligodendrocyte lineage defined by reactivity of progenitors with R-mAb prior to O1 anti-galactocerebroside. J. Neurosci. Res. 1992, 32, 309–316. [Google Scholar] [CrossRef]
- Kabata-Pendias, A. Agricultural problems related to excessive trace metal contents of soils. In Heavy Metals; Springer: Berlin/Heidelberg, Germany, 1995; pp. 3–18. [Google Scholar]
- Garland, J.L.; Mills, A.L. Classification and characterization of heterotrophic microbial communities on the basis of patterns of community-level sole-carbon-source utilization. Appl. Environ. Microbiol. 1991, 57, 2351–2359. [Google Scholar] [CrossRef] [Green Version]
- Congeevaram, S.; Dhanarani, S.; Park, J.; Dexilin, M.; Thamaraiselvi, K. Biosorption of chromium and nickel by heavy metal resistant fungal and bacterial isolates. J. Hazard. Mater. 2006, 146, 270–277. [Google Scholar] [CrossRef]
- Dixit, R.; Malaviya, D.; Pandiyan, K.; Singh, U.B.; Sahu, A.; Shukla, R.; Paul, D. Bioremediation of heavy metals from soil and aquatic environment: An overview of principles and criteria of fundamental processes. Sustainability 2015, 7, 2189–2212. [Google Scholar] [CrossRef] [Green Version]
- Presser, H.B. Employment schedules among dual-earner spouses and the division of household labor by gender. Am. Sociol. Rev. 1994, 59, 348–364. [Google Scholar] [CrossRef]
- Song, B.; Zeng, G.; Gong, J.; Liang, J.; Xu, P.; Liu, Z.; Ye, S. Evaluation methods for assessing effectiveness of in situ remediation of soil and sediment contaminated with organic pollutants and heavy metals. Environ. Int. 2017, 105, 43–55. [Google Scholar] [CrossRef] [PubMed]
- Mulligan, C.N.; Yong, R.N.; Gibbs, B.F. Remediation technologies for metal-contaminated soils and groundwater: An evaluation. Eng. Geol. 2001, 60, 193–207. [Google Scholar] [CrossRef]
- Yao, Y.; Gao, B.; Chen, J.; Zhang, M.; Inyang, M.; Li, Y.; Yang, L. Engineered carbon (biochar) prepared by direct pyrolysis of Mg-accumulated tomato tissues: Characterization and phosphate removal potential. Bioresour. Technol. 2012, 138, 8–13. [Google Scholar] [CrossRef]
- Mehmood, S.; Ahmed, W.; Alatalo, J.M.; Mahmood, M.; Imtiaz, M.; Ditta, A.; Ali, E.F.; Abdelrahman, H.; Slaný, M.; Antoniadis, V.; et al. Herbal plants-and rice straw-derived biochars reduced metal mobilization in fishpond sediments and improved their potential as fertilizers. Sci. Total Environ. 2022, 826, 154043. [Google Scholar] [CrossRef]
- Song, W.; Gao, B.; Xu, X.; Xing, L.; Han, S.; Duan, P.; Jia, R. Adsorption-desorption behavior of magnetic amine/Fe3O4 functionalized biopolymer resin towards anionic dyes from wastewater. Bioresour. Technol. 2016, 210, 123–130. [Google Scholar] [CrossRef]
- Hodson, A.; Tranter, M.; Vatne, G. Contemporary rates of chemical denudation and atmospheric CO2 sequestration in glacier basins: An Arctic perspective. Earth Surf. Process. Landf. 2000, 25, 1447–1471. [Google Scholar] [CrossRef]
- Lim, J.W.; Chen, C.L.; Ho, I.J.; Wang, J.Y. Study of microbial community and biodegradation efficiency for single-and two-phase anaerobic co-digestion of brown water and food waste. Bioresour. Technol. 2013, 147, 193–201. [Google Scholar] [CrossRef]
- Soares, H.M.V.M.; Boaventura, R.A.R.; Machado, A.A.S.C.; Da-Silva, J.E. Sediments as monitors of heavy metal contamination in the Ave River basin (Portugal): Multivariate analysis of data. Environ. Pollut. 1999, 105, 311–323. [Google Scholar] [CrossRef]
- Dermont, G.; Bergeron, M.; Mercier, G.; Richer-Laflèche, M. Soil washing for metal removal: A review of physical/chemical technologies and field applications. J. Hazard. Mater. 2008, 152, 1–31. [Google Scholar] [CrossRef] [PubMed]
- Jiang, M.; Griffin, W.M.; Hendrickson, C.; Jaramillo, P.; Van Briesen, J.; Venkatesh, A. Life cycle greenhouse gas emissions of Marcellus shale gas. Environ. Res. Lett. 2011, 6, 034014. [Google Scholar] [CrossRef]
- Leštan, D.; Luo, C.L.; Li, X.D. The use of chelating agents in the remediation of metal-contaminated soils: A review. Environ. Pollut. 2008, 53, 3–13. [Google Scholar] [CrossRef] [PubMed] [Green Version]
- Qiao, M.; Bai, Y.; Cao, W.; Huo, Y.; Zhao, X.; Liu, D.; Li, Z. Impact of secondary effluent from wastewater treatment plants on urban rivers: Polycyclic aromatic hydrocarbons and derivatives. Chemosphere 2017, 211, 185–191. [Google Scholar] [CrossRef]
- Ayangbenro, A.S.; Babalola, O.O. A new strategy for heavy metal polluted environments a review of microbial biosorbents. Int. J. Environ. Res. Public Health 2017, 14, 94. [Google Scholar] [CrossRef]
- Ojuederie, O.B.; Babalola, O.O. Microbial and plant-assisted bioremediation of heavy metal polluted environments: A review. Int. J. Environ. Res. Public Health 2017, 14, 1504. [Google Scholar] [CrossRef] [Green Version]
- Blaylock, M.J. Field demonstrations of phytoremediation of lead-contaminated soils. Phytoremediation of contaminated soil and water. In Phytoremediation of Contaminated Soil and Water; CRC: Boca Raton, FL, USA, 2020; pp. 1–12. [Google Scholar]
- Coelho, M.S.; Sales-Mellado, M.M. Effects of substituting chia (Salvia hispanica L.) flour or seeds for wheat flour on the quality of the bread. LWT-Food Sci. Tech. 2015, 60, 729–736. [Google Scholar] [CrossRef] [Green Version]
- Vangronsveld., J.; Herzig, R.; Weyens, N.; Boulet, J.; Adriaensen, K.; Ruttens, A.; Thewys, T.; Vassilev, A.; Meers, E.; Nehnevajova, E.; et al. Phytoremediation of contaminated soils and groundwater: Lessons from the field. Environ. Sci. Pollut. Res. 2009, 16, 765–794. [Google Scholar] [CrossRef]
- Birch, L.; Bachofen, R. Complexing agents from microorganisms. Experientia 1990, 46, 827–834. [Google Scholar] [CrossRef]
- Fogarty, R.V.; Tobin, J.M. Fungal melanins and their interactions with metals. Enzym. Microb. Technol. 1996, 19, 311–317. [Google Scholar] [CrossRef]
- Ledin, M. Accumulation of metals by microorganisms—Processes and importance for soil systems. Earth Sci. Rev. 2000, 51, 1–31. [Google Scholar] [CrossRef]
- Levinskaite, L. Effect of heavy metals on the individual development of two fungi from the genus Penicillium. Biologija 2001, 1, 25–30. [Google Scholar]
- Liaquat, F.; Munis, M.F.H.; Haroon, U.; Arif, S.; Saqib, S.; Zaman, W.; Khan, A.R.; Shi, J.; Che, S.; Liu, Q. Evaluation of metal tolerance of fungal strains isolated from contaminated mining soil of Nanjing, China. Biology 2020, 9, 469. [Google Scholar] [CrossRef] [PubMed]
- Zafar, S.; Aqil, F.; Ahmad, I. Metal tolerance and biosorption potential of filamentous fungi isolated from metal contaminated agricultural soil. Bioresour. Technol. 2007, 98, 2557–2561. [Google Scholar] [CrossRef]
- Nelson, D.W.; Sommers, L. Total carbon, organic carbon, and organic matter. Methods Soil Anal. Part 2 Chem. Microbiol. Prop. 1983, 9, 539–579. [Google Scholar]
- McLean, E.O. Soil pH and lime requirement. Methods Soil Anal. Part 2 Chem. Microbiol. Prop. 1983, 9, 199–224. [Google Scholar]
- Estefan, G.; Sommer, R.; Ryan, J. Methods of soil, plant, and water analysis. Man. West Asia North Afr. Reg. 2013, 3, 7–211. [Google Scholar]
- Hakanson, L. An ecological risk index for aquatic pollution control. A sedimentological approach. Water Res. 1980, 14, 975–1001. [Google Scholar] [CrossRef]
- Faiz, Y.; Tufail, M.; Javed, M.T.; Chaudhry, M.M. Road dust pollution of Cd, Cu, Ni, Pb and Zn along Islamabad expressway, Pakistan. Microchem. J. 2009, 92, 186–192. [Google Scholar] [CrossRef]
- Muller, G. The heavy metal pollution of the sediments of Neckars and its tributary: A stocktaking. Chem. Zeit. 1981, 105, 157–164. [Google Scholar]
- Loska, K.; Wiechuła, D.; Korus, I. Metal contamination of farming soils affected by industry. Environ. Int. 2004, 30, 159–165. [Google Scholar] [CrossRef]
- Nemerow, N.L. Stream, Lake, Estuary, and Ocean Pollution; Van Nostrand Reinhold Publishing Co: New York, NY, USA, 1991. [Google Scholar]
- White, T.J.; Bruns, T.; Lee, S.J.W.T.; Taylor, J. Amplification and direct sequencing of fungal ribosomal RNA genes for phylogenetics. Methods Appl. Fluoresc. 1990, 18, 315–322. [Google Scholar]
- Iram, S.; Zaman, A.; Iqbal, Z.; Shabbir, R. Heavy metal tolerance of fungus isolated from soil contaminated with sewage and industrial wastewater. Pol. J. Environ. Stud. 2013, 22, 691–697. [Google Scholar]
- Fu, Y.Q.; Li, S.; Zhu, H.Y.; Jiang, R.; Yin, L.F. Biosorption of copper (II) from aqueous solution by mycelial pellets of Rhizopus oryzae. Afr. J. Biotech. 2012, 11, 1403–1411. [Google Scholar]
- Tiwari, S.; Singh, S.N.; Garg, S.K. Microbially enhanced phytoextraction of heavy-metal fly-ash amended soil. Commun. Soil Sci. Plant Anal. 2013, 44, 3161–3176. [Google Scholar] [CrossRef]
- Konetzka, W.A. Microbiology of metal transformations. In Microorganisms and Minerals; Marcel Dekker: New York, NY, USA, 1977; pp. 317–342. [Google Scholar]
- Zapotoczny, S.; Jurkiewicz, A.; Tylko, G.; Anielska, T.; Turnau, K. Accumulation of copper by Acremonium pinkertoniae, a fungus isolated from industrial wastes. Microbiol. Res. 2007, 162, 219–228. [Google Scholar] [CrossRef]
- Samuel, A.D.; Tit, D.M.; Melinte, C.E.; Iovan, C.; Purza, L.; Gitea, M.; Bungau, S. Enzymological and physicochemical evaluation of the effects of soil management practices. Rev. Chim. 2017, 68, 2243–2247. [Google Scholar] [CrossRef]
- Samuel, A.D.; Brejea, R.; Domuta, C.; Bungau, S.; Cenusa, N.; Tit, D.M. Enzymatic indicators of soil quality. J. Environ. Prot. Ecol. 2017, 18, 871–878. [Google Scholar]
- Farhan, S.N.; Khadom, A.A. Biosorption of heavy metals from aqueous solutions by Saccharomyces cerevisiae. Int. J. Ind. Chem. 2015, 6, 119–130. [Google Scholar] [CrossRef] [Green Version]
- Puig, S.; Thiele, D.J. Molecular mechanisms of copper uptake and distribution. Curr. Opin. Chem. Biol. 2002, 6, 171–180. [Google Scholar] [CrossRef]
- Tu, C.; Liu, Y.; Wei, J.; Li, L.; Scheckel, K.G.; Luo, Y. Characterization and mechanism of copper biosorption by a highly copper-resistant fungal strain isolated from copper-polluted acidic orchard soil. Environ. Sci. Pollut. Res. 2018, 25, 24965–24974. [Google Scholar] [CrossRef] [PubMed]
- Behl, T.; Kaur, I.; Sehgal, A.; Singh, S.; Sharma, N.; Bhatia, S.; Al-Harrasi, A.; Bungau, S. The dichotomy of nanotechnology as the cutting edge of agriculture: Nano-farming as an asset versus nanotoxicity. Chemosphere 2022, 288, 132533. [Google Scholar] [CrossRef] [PubMed]
- Kowshik, M.; Nazareth, S. Metal tolerance of Fusarium solani. Ecol. Environ. Conserv. 2000, 6, 391–395. [Google Scholar]

| Sample | EC (dS/m) | pH | Organic Matter (%) |
|---|---|---|---|
| IS1 | 2.244 | 7.70 | 1.20 |
| IS2 | 2.19 | 7.60 | 1.52 |
| IS3 | 2.56 | 7.90 | 0.90 |
| IS4 | 2.60 | 8.25 | 0.82 |
| IS5 | 2.17 | 7.55 | 1.56 |
| Mean | 2.35 | 7.8 | 1.2 |
| STD | ±0.21 | ±0.28 | ±0.07 |
| Sample | Nitrogen (mg/kg) | Phosphorus (mg/kg) | Potassium (mg/kg) |
|---|---|---|---|
| IS1 | 5.32 | 10.10 | 59 |
| IS2 | 5.59 | 11.09 | 63 |
| IS3 | 4.45 | 8.19 | 40 |
| IS4 | 4.30 | 8.56 | 47 |
| IS5 | 6.3 | 12.15 | 62 |
| Mean | 5.19 | 10.01 | 54.2 |
| STD | ±0.83 | ±1.67 | ±7.18 |
| Sample | Cd (mg/kg) | Cu (mg/kg) | Pb (mg/kg) | Zn (mg/kg) |
|---|---|---|---|---|
| IS1 | 49.57 | 252.7 | 29.5 | 170.9 |
| IS2 | 46.8 | 300.4 | 16.4 | 150.49 |
| IS3 | 54.5 | 279.1 | 25.6 | 120.6 |
| IS4 | 56.1 | 260.4 | 21.7 | 90.8 |
| IS5 | 55.8 | 190.2 | 14.1 | 61.75 |
| Mean | 52.55 | 256.56 | 21.46 | 118.91 |
| STD | ±4.15 | ±31.42 | ±2.35 | ±20.04 |
| Pollution Index of Individual Metals | |||||
|---|---|---|---|---|---|
| Cd | Cu | Pb | Zn | PI | Grading |
| 9.134 | 11.140 | 0.410 | 1.616 | 8.220 | Severely polluted |
| Strains | Colony Features on PDA Media | Microscopic Characteristics |
|---|---|---|
| MS5 | Surface of colony was flat and velvety in texture. The color of mycelia was dark green, and the backside was yellowish cream. Marginal areas were pale blue–green and shading to blue–green towards the colony center. Older colonies became jade green in color | The hyphae were septate, branched and unicellular conidia could be observed. Conidia were colorless, unicellular, oval and rough (Figure 3. Conidiophores were biverticillate, asymmetrical and smooth walled. |
| PS1 | The color of mycelia was creamy white and pinkish. | Monophialides and sporodochia were the site for production of conidia. It was observed that macroconidia were somewhat sickle-shaped or falcate, thin-walled and septate (3–5) with pointed ends. While microconidia were elliptical or kidney-shaped, non-septate and occurred separately. |
| R7 | Whitish aerial mycelia | Septate hyaline hyphae were observed. Phialides were attached to conidiophores. |
| MH3 | Mycelia was greenish in color | Oval conidia could be observed. Phialides of 5–7 levels were present. |
| Strains | Minimum Inhibitory Concentrations (MICs) | |
|---|---|---|
| Cadmium | Copper | |
| MS5 | 1000 | 600 |
| PS1 | 400 | 800 |
| R7 | 800 | 600 |
| MH3 | 600 | 600 |
Publisher’s Note: MDPI stays neutral with regard to jurisdictional claims in published maps and institutional affiliations. |
© 2022 by the authors. Licensee MDPI, Basel, Switzerland. This article is an open access article distributed under the terms and conditions of the Creative Commons Attribution (CC BY) license (https://creativecommons.org/licenses/by/4.0/).
Share and Cite
Akbar, M.; El-Sabrout, A.M.; Shokralla, S.; Mahmoud, E.A.; Elansary, H.O.; Akbar, F.; Din, B.u.; Haroon, U.; Ali, M.; Saleem, H.; et al. Preservation and Recovery of Metal-Tolerant Fungi from Industrial Soil and Their Application to Improve Germination and Growth of Wheat. Sustainability 2022, 14, 5531. https://doi.org/10.3390/su14095531
Akbar M, El-Sabrout AM, Shokralla S, Mahmoud EA, Elansary HO, Akbar F, Din Bu, Haroon U, Ali M, Saleem H, et al. Preservation and Recovery of Metal-Tolerant Fungi from Industrial Soil and Their Application to Improve Germination and Growth of Wheat. Sustainability. 2022; 14(9):5531. https://doi.org/10.3390/su14095531
Chicago/Turabian StyleAkbar, Mahnoor, Ahmed M. El-Sabrout, Shadi Shokralla, Eman A. Mahmoud, Hosam O. Elansary, Fizza Akbar, Burhan ud Din, Urooj Haroon, Musrat Ali, Hira Saleem, and et al. 2022. "Preservation and Recovery of Metal-Tolerant Fungi from Industrial Soil and Their Application to Improve Germination and Growth of Wheat" Sustainability 14, no. 9: 5531. https://doi.org/10.3390/su14095531
APA StyleAkbar, M., El-Sabrout, A. M., Shokralla, S., Mahmoud, E. A., Elansary, H. O., Akbar, F., Din, B. u., Haroon, U., Ali, M., Saleem, H., Anar, M., Kamal, A., Tahir, K., Ahmed, J., Zubair, M. S., Javed Chaudhary, H., & Munis, M. F. H. (2022). Preservation and Recovery of Metal-Tolerant Fungi from Industrial Soil and Their Application to Improve Germination and Growth of Wheat. Sustainability, 14(9), 5531. https://doi.org/10.3390/su14095531








